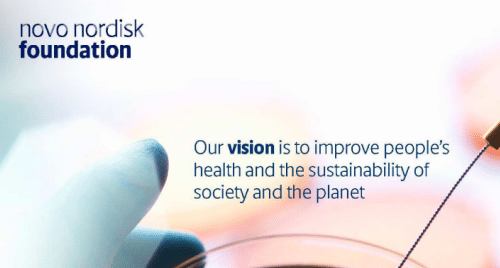

Document generation
Streamline your reporting process and elevate your brand
Don’t waste time and resources creating reports from scratch, use our report templates and double down on your productivity and efficiency.
Try our report templates now and see the difference they can make to your business.
Work smarter with branded templates, real-time data integration, and intuitive tools for high-stakes business documents
Professional reporting at scale - without compromising creativity or control
At Omnidocs, we design and implement reporting solutions that power your most important business documents like annual reports, ESG disclosures, board decks, and strategic plans.
With 20+ years of experience and partnerships with leading enterprises and design agencies, we create custom templates that balance flexibility with structure. The result? Teams work faster, stay on-brand, and collaborate more effectively, without the chaos of working from scratch.
Empower your people. Protect your brand. Improve your process.
Why our clients use Omnidocs templates.
Our templates are more than just good-looking documents. They’re strategic tools built to make reporting more accurate, more collaborative, and more efficient at every step.
Always on-brand
Visual and tonal consistency across every report, no matter who’s editing.
Collaborate without confusion
Work in parallel across departments or locations with structured templates that support real teamwork.
Save time where it counts
Stop formatting, start writing. Our templates remove the friction from layout and structure.
Live data, no rework
Integrate Excel data directly into Word or PowerPoint with automatic syncing – goodbye manual updates.
Compliance built in
Templates follow your visual identity and regulatory guidelines ensuring consistency and peace of mind.
Scale with ease
Whether you’re creating 1 or 100 reports, our solutions are made to support teams across geographies and languages.
Watch how a global design icon created more freedom, more efficiency, and more brand impact
How Bang & Olufsen reimagined their annual report process
“There are high expectations to what Bang & Olufsen stands for, and that has to be reflected in our corporate reporting.
We now control the document and the process – this gives us better results, more flexibility, and real ownership of our reporting.”
Watch how Arla created their award-winning 150-page annual report in Word; 6 languages, 150 pages, tables, visuals, and custom layouts.
Built for real teams, real needs, real complexity.
Tight deadlines, brand inconsistencies, or scattered workflows?
Book a free session
Talk with one of our document specialists and discover how a smarter approach to templates can transform your reporting.